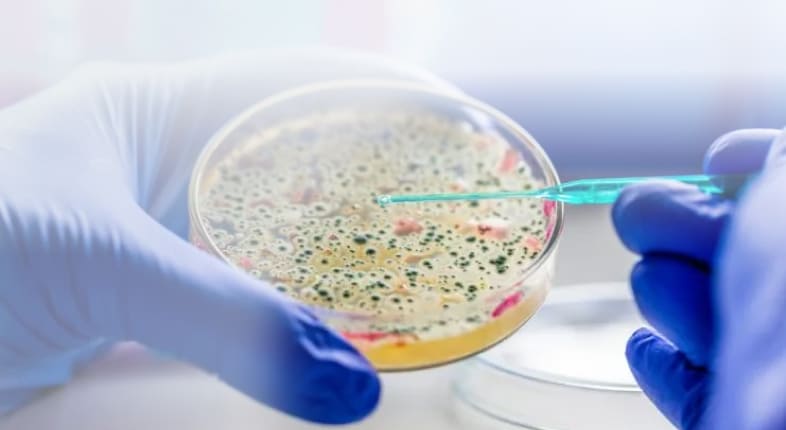
Бактериальный посев на чувствительность к антибиотикам

Бактериальный посев на чувствительность к АБ (жен., уроген.тракт, церв.канал)
- Главная
- Услуги
- Гинекология
- Бакпосев и антибиотикограмма
- Бактериальный посев на чувствительность к антибиотикам
Бактериальный посев на чувствительность к антибиотикам
Цены
Бак.посев, чувств. к АБ (жен., уроген.тракт, церв.канал)55.93 р.
